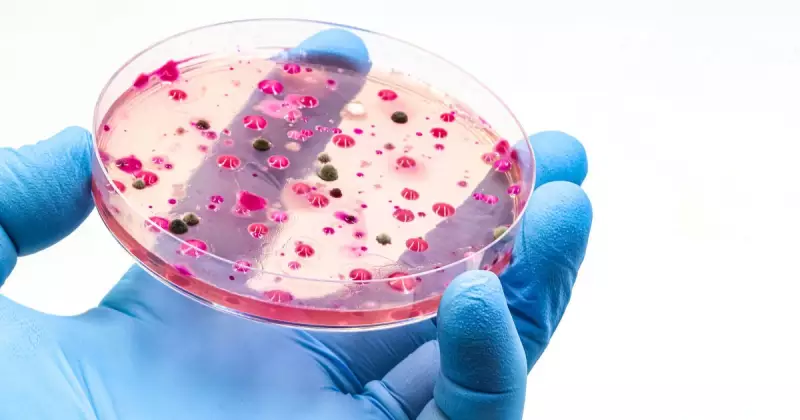

Hospitals across England are grappling with a significant surge in cases of an aggressive pneumonia strain that medical professionals have dubbed 'white lung' pneumonia. The outbreak has prompted urgent responses from multiple NHS trusts as cases continue to rise.
What is 'White Lung' Pneumonia?
The term 'white lung' refers to how the infection appears on chest X-rays, where the lungs show extensive white areas indicating severe inflammation and fluid buildup. This particular outbreak is primarily caused by mycoplasma pneumoniae, a bacterial infection that spreads through coughs and sneezes.
Regions Most Affected
Health officials have reported concerning case clusters in several areas including:
- Southwest England
- Northeast regions
- Multiple major hospital trusts across the country
The outbreak is notably affecting both children and adults, with some patients requiring hospitalisation for oxygen support and intensive treatment.
NHS Emergency Response
Hospital trusts have implemented several measures to manage the surge:
- Increased bed capacity for respiratory cases
- Enhanced infection control protocols
- Staff redeployment to affected areas
- Extended opening hours for respiratory assessment units
- Persistent cough lasting more than three weeks
- Difficulty breathing or shortness of breath
- Chest pain that worsens when breathing or coughing
- High fever and general fatigue
- Bluish discolouration of lips or fingernails in severe cases
Symptoms to Watch For
Medical experts advise the public to be alert for key symptoms including:
Professor Sir Stephen Powis, NHS national medical director, confirmed that hospitals are "monitoring the situation closely" and have "robust plans in place" to manage the increased demand for respiratory services.
Prevention and Protection
Health authorities emphasise that good hygiene remains the best defence against infection spread. Regular hand washing, covering coughs and sneezes, and staying home when unwell can significantly reduce transmission risk.
While current cases remain manageable, health officials are closely monitoring the situation and preparing for potential further increases during the winter months when respiratory infections typically peak.